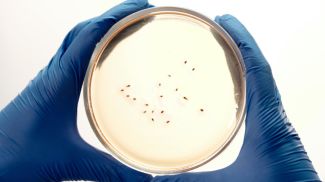
Фото Pexels

Танкер Rich Starry под флагом Малави, принадлежащий китайской компании и находящийся под санкциями США, прошел через Ормузский пролив после объявления морской блокады. Об этом сообщает РИА Новости со ссылкой на CNN.
Согласно данным сервиса Marine Traffic, судно пересекло пролив сегодня утром. Накануне вечером танкер уже пытался покинуть Персидский залив, но развернулся в районе острова Кешм.
По информации телеканала, на борту танкера находится метанол, а пунктом назначения указан Китай.
Судно принадлежит компании Full Star Shipping и с 2023 года находится под американскими санкциями за сотрудничество с Ираном.
Социум
14 апреля 2026, 11:07
CNN: китайский танкер под санкциями США прошел через Ормузский пролив
Главное

- размещаются материалы рекламно-информационного характера.
- размещаются материалы рекламно-информационного характера.